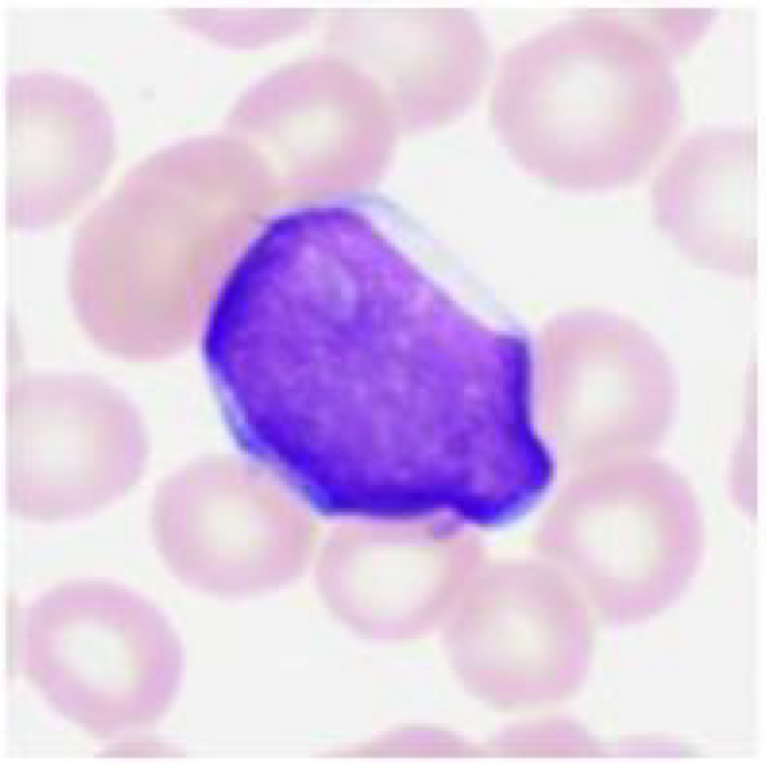
<p>3 yo female presents with exertional dyspnea, fever, petechiae & gingival bleeding, and headache. She is <strong>febrile and anemic</strong> (hematocrit 25%, normal range 36-54%) and has a WBC count of 20,000/mm³ (normal range 8-10,000). She has generalized <strong>lymphadenopathy (enlarged lymph nodes) & splenomegaly</strong>. The peripheral revealed numerous immature blasts with <strong>scant agranular cytoplasm</strong>. What is most likely the diagnosis?</p>

1/59
Looks like no tags are added yet.
Name | Mastery | Learn | Test | Matching | Spaced | Call with Kai |
|---|
No analytics yet
Send a link to your students to track their progress
What is tumor grading?
assessing appearance of cancer cells under a microscope & how abnormal they are
What are the 3 categories of differentiation for tumor grading and how are they determined?
“well” differentiated: close resemblance to parent cell
> for glandular: ability to form glands
> for squamous epithelium: ability to form keratins
“poorly” differentiated: more primitive changes
“moderately” differentiated: between well and poorly differentiated
What are the tiers for the 3 tier system of tumor grading?
Grade 1 - well differentiated
Grade 2 - moderately differentiated
Grade 3 - poorly differentiated
What are the tiers for the 2 tier system of tumor grading?
low grade (grade 1) and high grade (grade 2 & 3)
What is tumor staging?
determining whether the tumor has spread to nearby areas or other parts of the body. TNM system most commonly used.
What does TNM mean for tumor staging?
T: size & extent of primary tumor
N: number of lymph node metastases
M: distant metastasis
What are staging systems other than TNM?
Breslow & Clark staging system of melanoma
FIGO staging for endometrial carcinoma
Which of the following is a benign neoplasm?
Lymphoma
Adenoma
Melanoma
Seminoma
Mesothelioma
Adenoma
What does malignant mean?
infiltrates surrounding tissues with the potential to metastasize
What are the histologic features that generally distinguish benign from malignant tumors?
malignant tumors have lots of mitotic figures
What are features of benign tumors?
cells resemble normal cells - well differentiated; well defined borders
well circumscribed (encapsulated)
localized - do not invade surrounding normal tissue or spread to other sites
slow growing
What are features of malignant tumors?
malignant cellular changes (dysplasia —> loss of differentiation —> anaplasia); poorly defined borders
local invasion & destruction of adjacent tissues
spread to distant sites (metastasis)
rapid growth
A germline mutation in which gene leads to the development of colorectal adenocarcinoma in familial adenomatous polyposis?
APC
What is a microsatellite?
short DNA sequence that is repeated many times
accumulation of microsatellites is a marker of dysplasia & ultimately carcinoma
Describe the microsatellite instability pathway in the development of colorectal carcinoma
functional defect in mismatch repair genes; accounts for 15% of sporadic colorectal carcinoma.
caused by aberrant MMR genes — leads to microsatellites which are prone to mutations
this is a common mechanism of colorectal carcinoma arising in patients with Lynch Syndrome.


what is the diagnosis?
invasive colonic adenocarcinoma (forming glands)
Which of the following is considered a dysplastic colon polyp?
Tubular adenoma
Hyperplastic polyp
Inflammatory pseudopolyp
Mucosal prolapse
Mucosal polypoidoma
Tubular adenoma — can potentially progress to colorectal cancer if left untreated
What does dysplastic mean?
tending toward malignancy
What type of cells give rise for cholangiocarcinoma?
arises from bile duct epithelial cells (either intrahepatic or extrahepatic)
Which viruses are most commonly associated with acute viral hepatitis?
Hep A & Hep E
Which organism is most commonly associated with chronic gastritis?
Helicobacter pylori - associated with ulcers

52 yo female with GERD for past 10 years undergoes upper GI endoscopy to reveal an irregular gastroesophageal junction with salmon-pink colored mucosa. What kind of cells are present in the salmon-pink region?
likely indicative of Barrett’s esophagus — normal squamous epithelium of distal esophagus is replaced by metaplastic columnar epithelium (intestinal metaplasia - goblet cells).
cells become more glandular to protect themselves

65 yo obese male with hematuria and a flank mass. What is the diagnosis of this renal cancer?
clear cell carcinoma
What is hydronephrosis?
accumulation of urine within the kidney due to blockage in ureter (excess fluid in kidney)
What can commonly cause hydronephrosis?
kidney stones, benign prostatic hyperplasia (prostate issues)
What complications can result from hydronephrosis?
UTIs, kidney damage/failure, high blood pressure

What is the diagnosis?
benign prostatic hyperplasia

what is the diagnosis?
urothelial carcinoma
What is septic shock?
most severe stage of sepsis
life threatening condition caused by the body’s extreme response to an infection
due to overwhelming bacterial infection
What is the most common origin of a pulmonary embolus?
95% originate from deep vein thrombosis (DVT) above the knee —> clots break free and travel to lungs where they block an artery
What is a hemothorax?
condition where blood accumulates in pleural cavity —> puts pressure on lungs, potentially making them collapse/making it difficult to breathe
What cells infiltrate the heart muscle soon after myocardial infarction?
neutrophils followed by monocytes which differentiate into macrophages
what are the commensal organisms of the oral cavity that can be causative organisms for subacute endocarditis?
endocarditis of previously damaged or otherwise abnormal valves is caused most commonly (50-60% of cases) by streptococci viridans
additional bacterial agents include enterococci & HACEK (Haemophilis, actinobacillus, cardiobacterium, eikenella, & kingella)
67 yo man with pain in legs and feet when walking more than 100 yards. Physical exam findings include the absence of palpable ankle pulses. Lab findings include a blood glucose level of 325 mg/dL. The pt is diagnosed with metabolic syndrome, which is defined as the coexistence of what risk factors for cardiovascular disease?
obesity, low HDL, high triglycerides, high blood pressure, insulin resistance
Which of the following is considered an indolent (slowly progressing) lymphoma?
Precursor Bcell lymphoma
Precursor Tcell lymphoma
Follicular lymphoma
Burkitt lymphoma
Diffuse large Bcell lymphoma
Follicular lymphoma
What virus is associated with Hodgkin lymphoma?
Epstein Barr Virus
3 yo female presents with exertional dyspnea, fever, petechiae & gingival bleeding, and headache. She is febrile and anemic (hematocrit 25%, normal range 36-54%) and has a WBC count of 20,000/mm³ (normal range 8-10,000). She has generalized lymphadenopathy (enlarged lymph nodes) & splenomegaly. The peripheral revealed numerous immature blasts with scant agranular cytoplasm. What is most likely the diagnosis?
Acute lymphoblastic leukemia/lymphoma (ALL)
What is an osteosarcoma?
bone-producing malignant mesenchymal tumor. most common primary bone tumor outside of myeloma & lymphoma (75% in pts under 20 yo).
Where do osteosarcomas usually arise?
most tumors arise in metaphyseal region of long bones, with almost 60% occurring toward knee, 15% in pelvic bone, 10% in proximal humerus, & 8% in jaw.
What gene mutations are seen in osteosarcomas?
Retinoblastoma gene mutations occur in 60-70% of sporadic tumors
Frequently exhibit mutations in genes that regulate cell cycle (P53, cyclins, cyclin-dependent kinases, & kinase inhibitors)
What is seen with osteogenesis imperfecta?
multiple skeletal deformities with abnormal body posture
extreme skeletal fragility, blue sclera, hearing loss, small misshapen teeth
Type 1 OI vs Type 2 OI
type 2 is uniformly fatal in utero or perinatal period
type 1 has normal life span, but with increased broken bones
What is achondroplasia?
most common skeletal dysplasia and a major cause of dwarfism
What mutation causes achondroplasia and how does it work?
autosomal dominant inheritance or spontaneous mutations (~80%), caused by gain of function point mutation in the fibroblast growth factor receptor 3 (FGFR3) that results in its constitutive activation.
activated FGFR3 inhibits chondrocyte proliferation, as a result the normal physeal growth plate expansion is suppressed, and endochondral ossification growth is severely stunted.
What does achondroplasia affect?
affects all bones that form from a cartilaginous framework:
disproportionate shortening of extremities (normal sized torso)
bowing of the legs
lordotic (sway-backed) posture
bulging forehead with depressed nasal bridge
no impact of sterility, longevity, or intelligence
What is osteopetrosis?
“marble bone disease,” characterized by reduced bone resorption and diffuse symmetric skeletal sclerosis due to impaired function of osteoclasts
What causes osteopetrosis?
attributed to inadequate acidification of osteoclast resorption pit, which is required for the dissolution of calcium hydroxyapatite within bone matrix
What is seen with osteopetrosis?
despite sclerosis, bones are paradoxically brittle and fracture easily
fractures, cranial nerve deficits, and recurrent infections seen
Pts often develop hepatosplenomegaly due to extramedullary hematopoiesis
What are the characteristics of the osteoid present in developing bone matrix?
organic component (35% of matrix)
proteins (type I collagen & noncollagenous proteins - osteopontin)
glycosaminoglycans
note: bone cells are also an organic component of bone, but create/remodel matrix
What is a medulloblastoma?
a malignant, primitive neuroectodermal tumor of the cerebellum.
typically in children
infratentorial
What is the cell type in a medulloblastoma?
embryonal cell
What does pilocytic astrocytoma look like under the microscope?
hair-like background
rosenthal fibers (thick, elongated, cork-screw structures)

What is a pilocytic astrocytoma?
who grade 1
benign behavior with surgical resection often curative
typically in cerebellum of children or young adults
tumors that extend into the hypothalamic region from the optic tract can have a more difficult course because of location
What is the significance of IDH mutation in gliomas?
associated with a better prognosis
often exhibit increased sensitivity to therapies like radiotherapy and chemotherapy
What is the molecular signature of oligodendrogliomas?
both IDH mutation and 1p/19q co-deletion are required for diagnosis of oligodendrogliomas

What is the diagnosis?
meningioma
What are the determinants of grading meningiomas?
Grade 1:
nuclei - oval with delicate chromatin and inconspicuous nucleoli
cytoplasm - pink with syncytial look
cellular whorls
psammoma bodies (circular calcifications)
What are the prognostic factors of breast cancer?
size of tumor, lymph node metastases, distant metastases, tumor grade, histologic type of carcinoma, estrogen & progesterone receptors, over-expression of HER2/NEU, lymphovascular space invasion
other: DNA content, proliferative rate, response to chemotherapy, gene expression profiling
What is the diagnosis commonly rendered when a lump is excised and it is determined to be benign?
fibroadenoma
What is a fibroadenoma?
most common benign neoplasm of the female breast
peak incidence: 2nd and 3rd decade
solitary or multiple/bilateral, discrete, mobile masses
almost no risk to malignancy
histology: arise from intralobular stroma and composed of benign epithelium (glands) and benign stroma